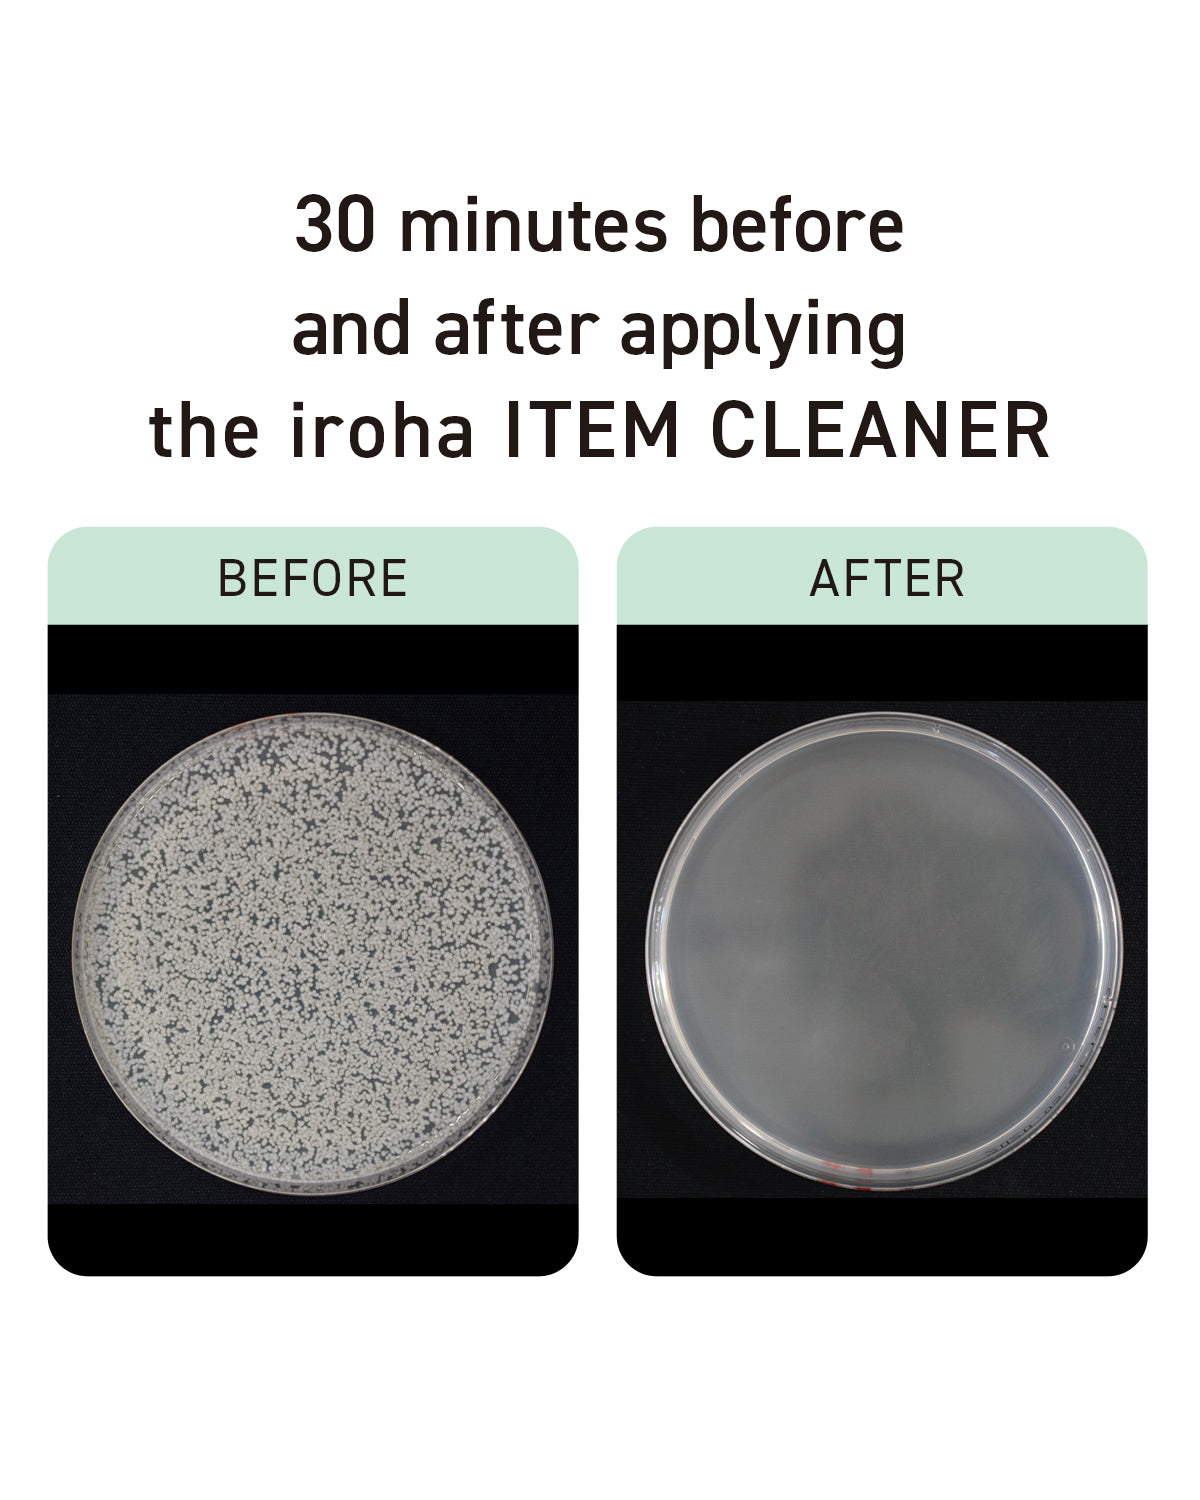

iroha ITEM CLEANER
Earn [points_amount] when you buy this item.


A loving cleanse for your iroha
In order to enjoy self-pleasure with peace of mind, it is important to take care of your iroha by properly cleaning them.
As something that comes in contact with your body, it should be made of ingredients that are gentle on the skin, and should be easy to use for daily care.


Apply with one push and wipe off with a tissue
Contains silver ions and mild ingredients to clean delicate items, plus it is mildly acidic so it can be freely used before or after a self-pleasure session.
Features

How to Use

Size (H × W × D): 5.16 in × 1.42 in × 1.42 in
Volume: 1.7 fl oz
Ingredients:
Water, Butylene Glycol, Decyl Glucoside, Tea-Cocoyl Glutamate, Silver Oxide, o-Cymen-5-ol, Citric Acid, Sodium Citrate, Phenoxyethanol
Note:
・Use directly on items and wipe off completely with a dry cloth or tissue.
・In case of any concerns, rinse off thoroughly.
・If you experience any skin issues, stop use immediately and contact a dermatologist.
・Keep away from hot, humid places and direct sunlight.
・Unscented
Choose options






